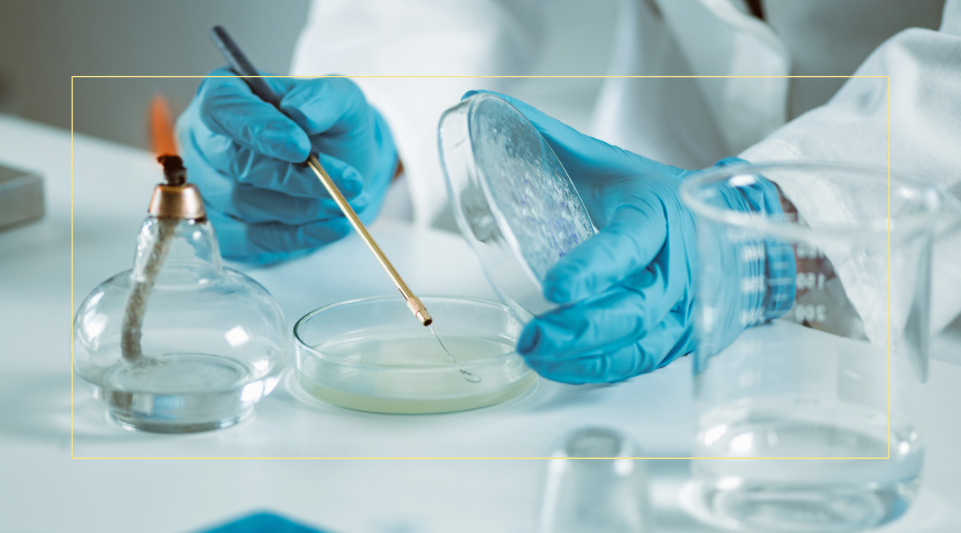

EaD
EaD
5 Cursos

CACIM: Curso de Actualización de Contenidos para el Ingreso a Medicina - 2º Edición
Comunicación y comprensión lectora
¡Bienvenidos al Curso de Comunicación y Comprensión Lectora!
